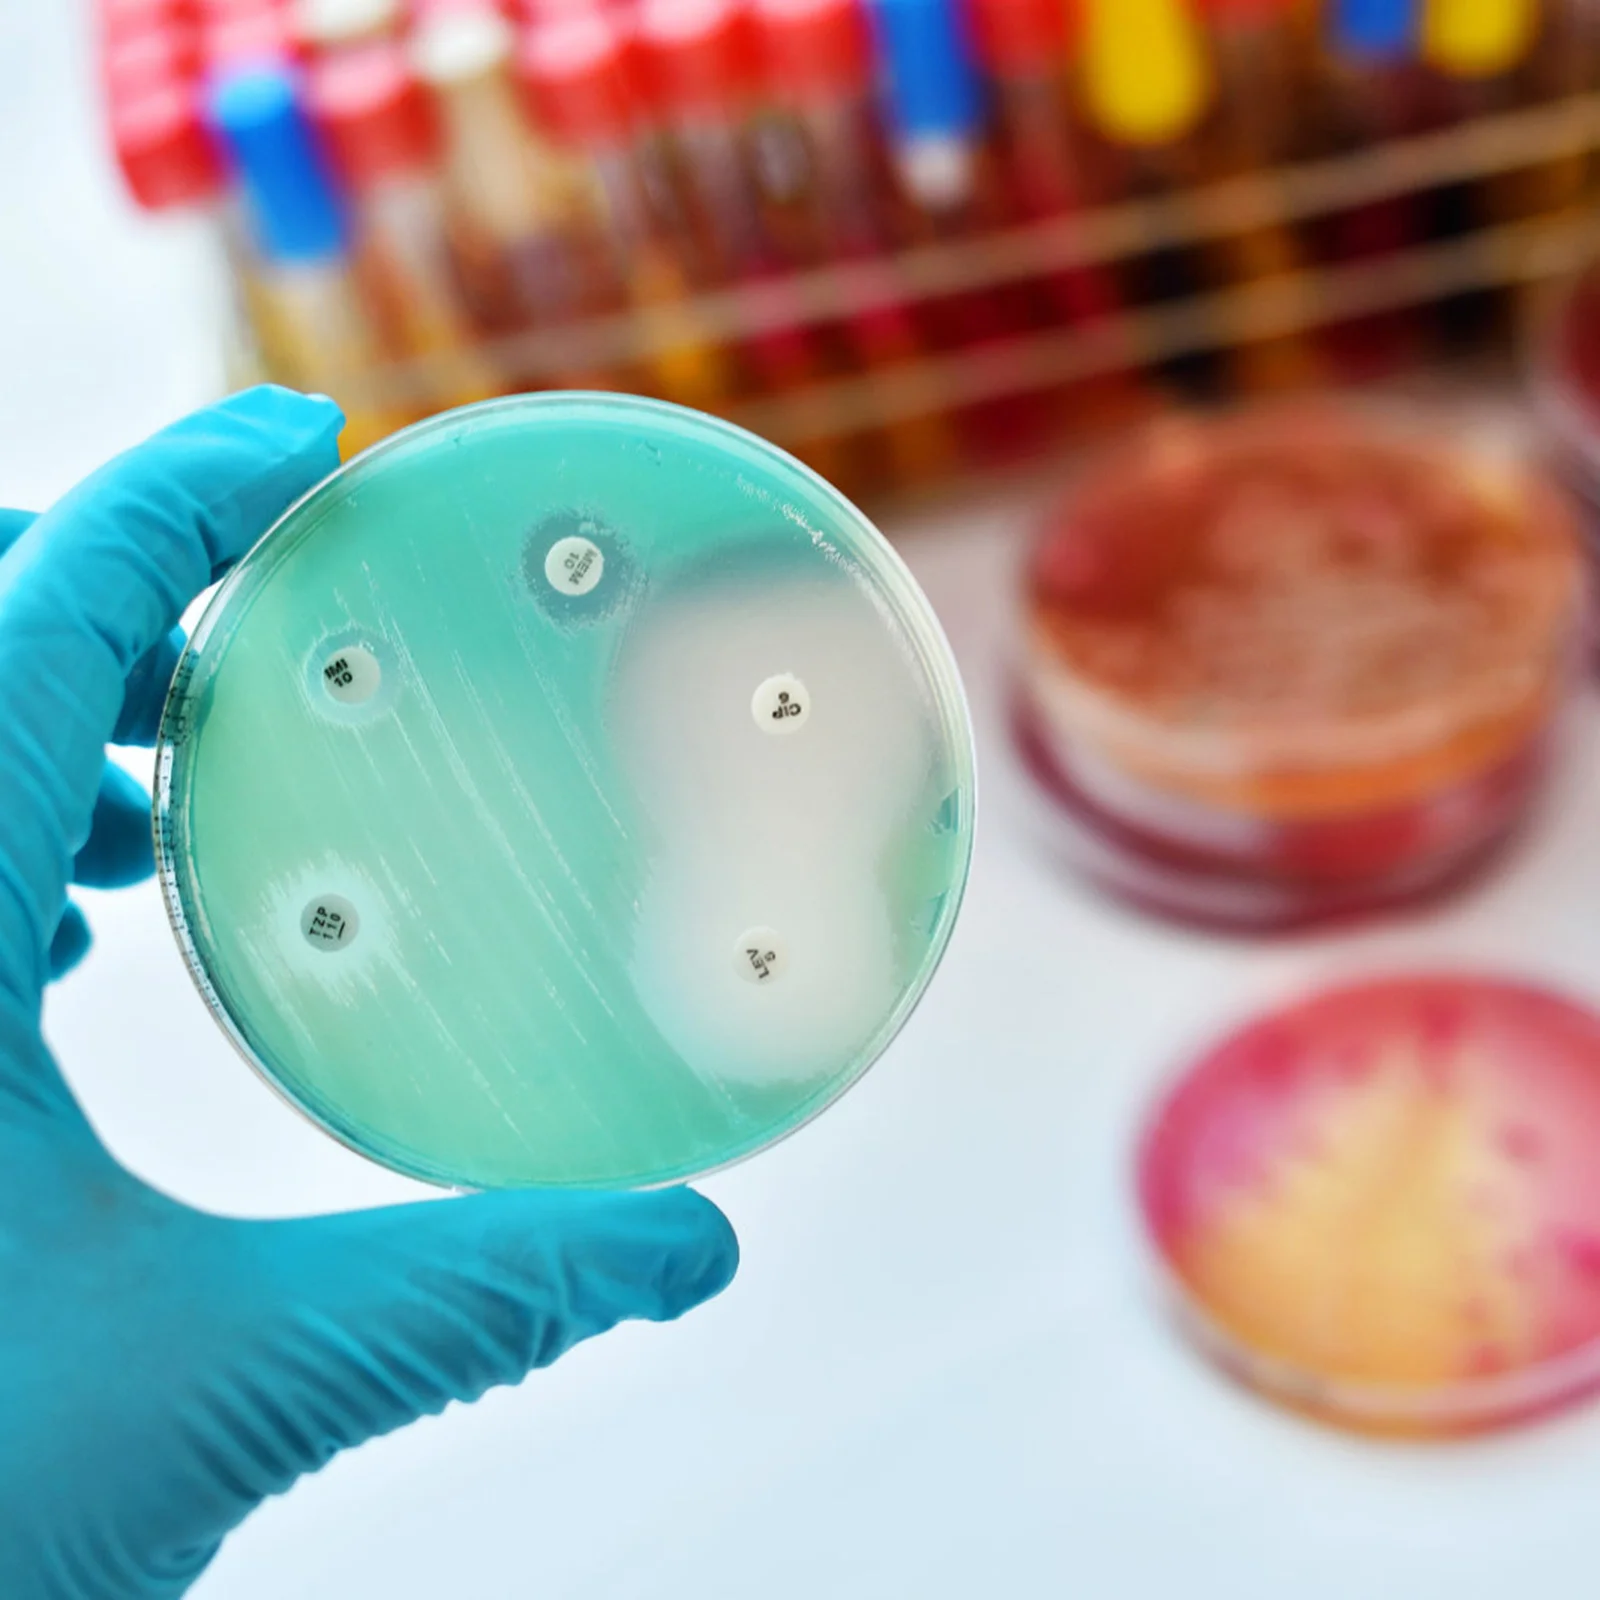

Тарелка Петри пластиковая с крышкой, 30 шт.
График изменения цены & курс обмена валют
Пользователи также просматривали

$7.27
Girls Sunflower Swimsuit 6 Women High Bikini Tops for Women Large Bust Sunflower Bathing Suits for Women Two Piece Shorts
aliexpress.com
$4.71
304 Stainless Steel Worm Clamp Hose Clamp Strap with Fasteners Adjustable DIY Pipe Hose Clamp Ducting Clamp 7.9Feet
aliexpress.com
$55.32
Женский костюм для косплея аниме отбеливатель Bambietta Basterbine, одежда, пальто, юбка, шапка, комплект для девочек на Хэллоуин, карнавал, ролевые игры
aliexpress.com
$641.15
17 Inch Stained Glass Table Lamp European Style Creative Decorative Living Room Lamp Bedroom Bedside Lamp
aliexpress.com
$25.08
Coin Capsules 30mm Plastic Coin Holders, Coin Collection Supplies with Foam Protect Gasket(17/20/25/27/30mm)-
aliexpress.com
$36.92
Rose Pink Straight Synthetic 13X4 Lace Front Wigs Glueless Hgh Quality Heat Resistant Fiber Hair Middle Parting For Women Wigs
aliexpress.com
$21.15
In Stock Bandai Banpresto Saint Seiya Cosmo Fantasy Cosmo Saint Seiya Pegasus Anime Figure Action Model Pvc Desktop Decoration
aliexpress.com
$57.94
2023 Winter New Sheepfold Wool Short Coat Long Sleeve Lapel Imitation Fur Silicon Soft Women's Warm All-matching Jacket
aliexpress.com
$292.50
Mermaid Flare Sleeve Evening Dresses For Women Luxury Beaded Rhinestone Women Prom Dresses Sexy Illusion Party Gown Vestidos
aliexpress.com
$36.10
Wholesale 5pcs Encoder 11PPR Micro Metal Gear Motor 25mm Reduction Motor Low Speed Low Noise Gearmotor For Smart Arduino Toy Car
aliexpress.com
$11.89
Black Bats Print Summer Tank Top Halloween Gothic Workout Tops Man Graphic Sportswear Sleeveless Shirts Plus Size 4XL 5XL
aliexpress.com
$10.63
Lyophilized eye mask paste collagen polypeptide snake venom peptide lyophilized powder to remove dark circles under the eyes
aliexpress.com
$29.99
Color and Paint compatible with Honda Motorcycle Touch Up Paint - HONDA DARK RED - HON.SR018.0 - Basic Care
aliexpress.com
$35.35
Women Zipper Fly Shorts Loose High Waist Spring Summer 2022 Female Straight Shorts
aliexpress.com
$4.76
Extra Strength for Energy, Muscle Growth, Cardiovascular & Endurance - Premium Arginine Nitric Oxide Supplement
aliexpress.com![[DEAT] Women Elegant Midi Dress Slit New Round Neck Half Sleeve Evening Party Dresses Fashion Spring Summer 2023 13DA3273
[DEAT] Women Elegant Midi Dress Slit New Round Neck Half Sleeve Evening Party Dresses Fashion Spring Summer 2023 13DA3273](http://ae04.alicdn.com/kf/S9a1a30caca1b4f9aa1db39f8189a4393t.jpg)
$111.33
[DEAT] Women Elegant Midi Dress Slit New Round Neck Half Sleeve Evening Party Dresses Fashion Spring Summer 2023 13DA3273
aliexpress.com
$10.40
Tower of Fantasy Table Mat Xxl Gaming Mouse Pad Gamer Rgb Backlight Big Mousepepad Back Light Deskmat Office Accessories Desk
aliexpress.com
$15.82
HOT 17 Inch Violin With Case Bow Stringed Instrument For Kids Students Beginner Toy Gift
aliexpress.com
$12.72
M92 Mini Keychain Military Fans Backpack Bags Decoration Pendant Gift Toy Detachable Tactical Pistols Gun Shape Keyring Set
aliexpress.com
$18.87
Plush Flower Handbag Fashion Cute Lady Bag Koreal Trend Winter Simple All-match Wallet Purse For Women
aliexpress.com
$8.21
Рюкзак-органайзер для женщин и мужчин, маленькая школьная сумка, модный дорожный уличный рюкзак для покупок с леопардовым принтом, повседневные многофункциональные сумки
aliexpress.ru
$8.90
Футболка с рисунком динозавра в полоску, мягкая утолщенная теплая молочная шелковая полоска с узором M серый
joom.com
$83.80
Lamy safari mit ergonomischem Griff schwarzer Stahlfeder в Strichbreite F фиалково-ежевичный Füller - Füllhalter & - ASA-Kunststoff - inkl.
joom.com
$26.21
Женская мода повседневное однотонное платье с круглым вырезом и пуговицами с открытыми плечами и коротким рукавом с карманом L чёрный
joom.com
$89.90
Мужской осенне-зимний простой домашний костюм из двух предметов: рубашка с длинными рукавами и брюки M
joom.com
$5.34
Бирюзовые серьги-подвески Серьги-кисточки с улитками Великолепные ювелирные серьги для девочек style 3
joom.com
$6.46
50 шт. Средство от звона в ушах, пластыри от звона в ушах, натуральные травяные пластыри от звона в ушах синий
joom.com
$76.60
КРАСОЧНЫЙ КОНФЕТНЫЙ СТИЛЬ Чехол для клавиатуры губной гармошки для девочек Чехол для пианики на плечо с плечевым ремнем Сумка для клавиатуры губной гармошки Сумка для пианики Unicorn Fantasy
joom.com![Мягкая грелка для короткого размера. Грелка для согрева всего тела. Отлично подходит для экономии энергии. Ноги CLO Z, [M Red] Обувь CLO Z, тело,
Мягкая грелка для короткого размера. Грелка для согрева всего тела. Отлично подходит для экономии энергии. Ноги CLO Z, [M Red] Обувь CLO Z, тело,](http://img.joomcdn.net/8ba30435bd40123601745e38bee7bf2eef756ccb_original.jpeg)
$228.18
Мягкая грелка для короткого размера. Грелка для согрева всего тела. Отлично подходит для экономии энергии. Ноги CLO Z, [M Red] Обувь CLO Z, тело,
joom.com
$3.89
Набор для вышивки крестиком 3631, рождественские товары, продвижение, бесплатная доставка, рукоделие «сделай сам», Набор тканевых ниток для в...
aliexpress.ru
$19.60
INSRPLS женские модные плиссированные спереди сбоку Стразы атласные брюки винтажные женские брюки со средней посадкой на молнии
aliexpress.ru
$11.74
7/8" 22mm Universal Motorcycle Handle grips Racing Handlebar Grip ends For Suzuki GSR600 750 GSXS 750 1000/F V-strom 650 SV650
aliexpress.ru
$76.08
Радиочастотное устройство для лифтинга лица, кавитационный ультразвуковой массажер для похудения и потери веса, светодиодное устройство с...
aliexpress.ru